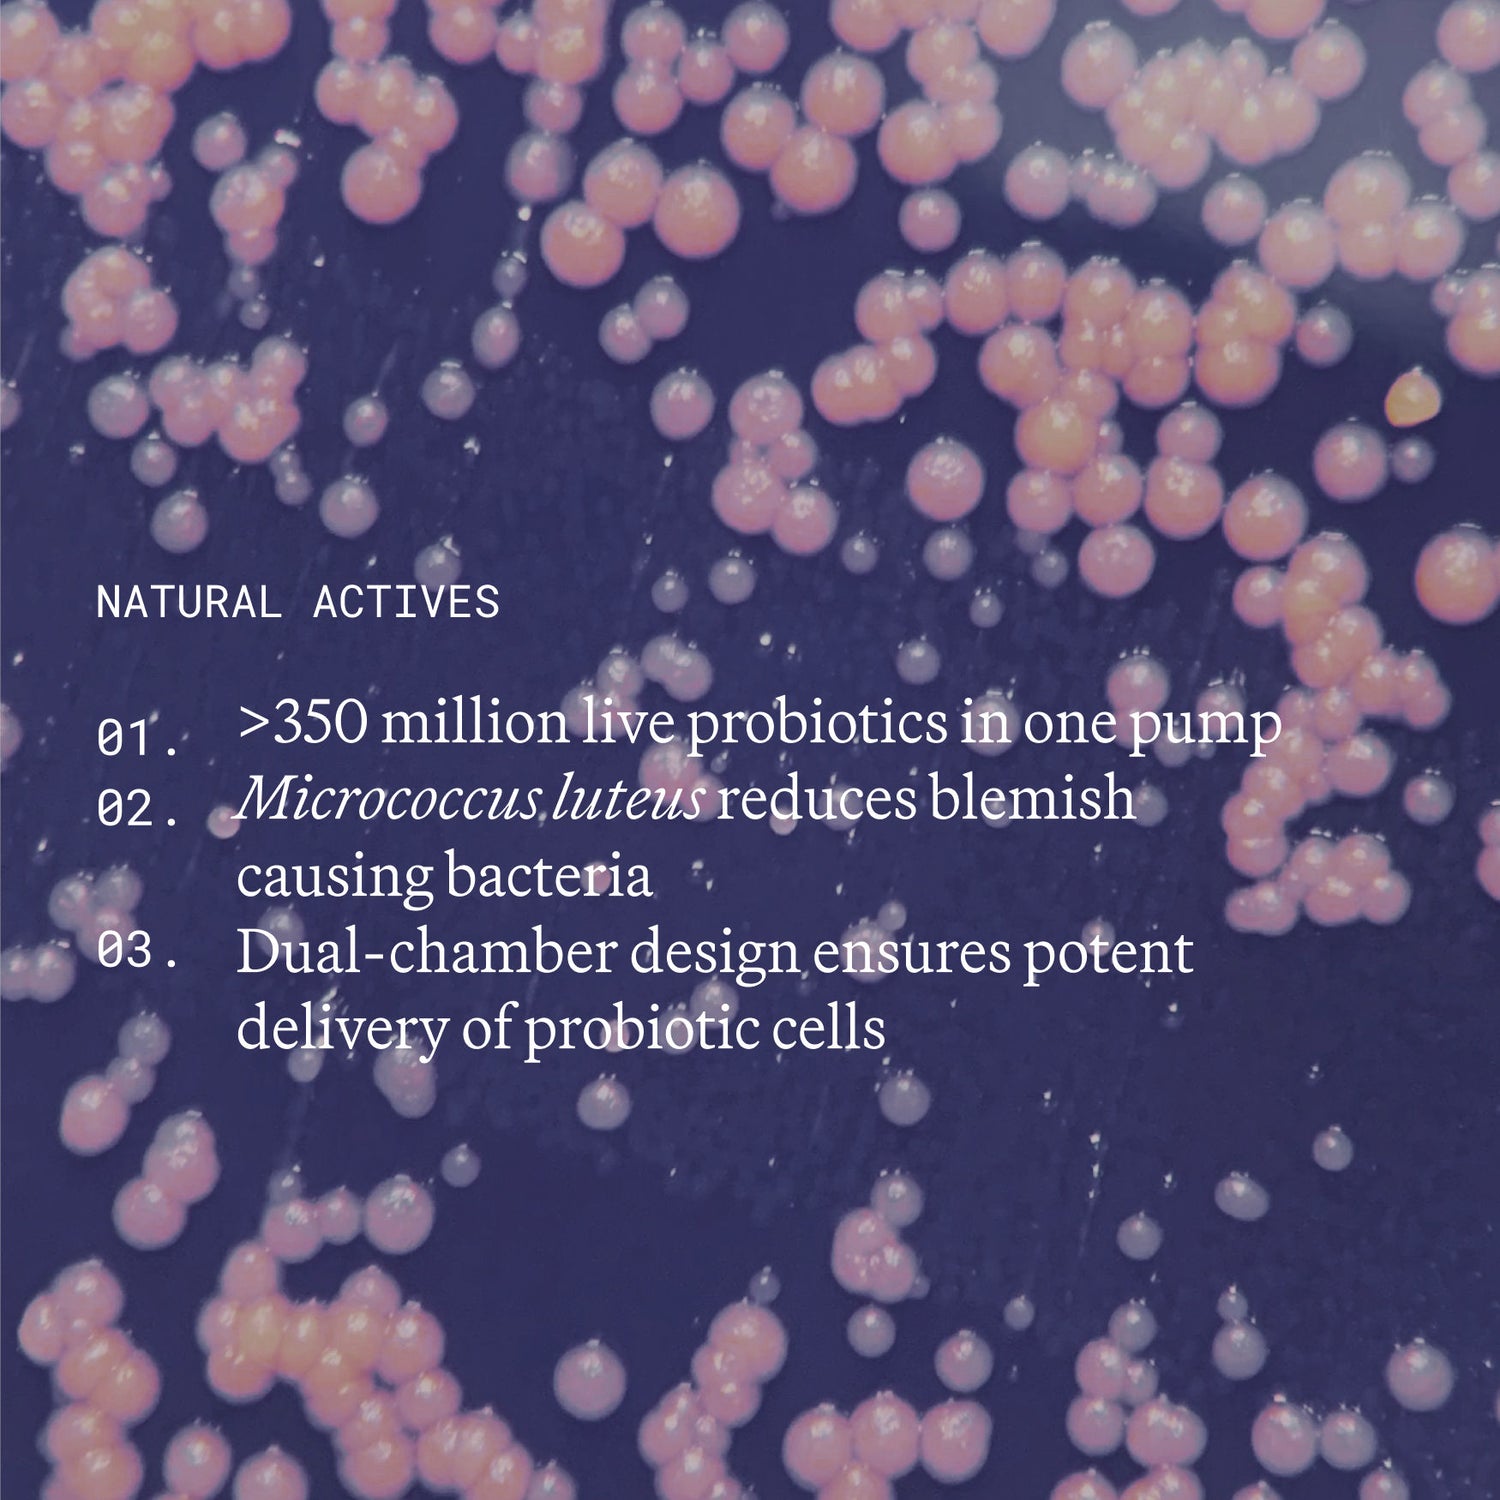
Information related to Emma Lewisham Supernatural Blemish Face Serum

Coming soon! Get notified when Supernatural Blemish Face Serum arrives
By continuing, you agree to Bluemercury's Privacy Practices.
Supernatural Blemish Face Serum is only available to BlueRewards members
Supernatural Blemish Face Serum
$66
Product Information
Product Information
Description
A flourishing microbiome is at the heart of clear, balanced, and radiant skin. This live probiotic serum harnesses 20 years of world-leading science to target blemishes and inflammation in a way that hasn’t been seen before. Delivering more than 350 million live beneficial probiotic cells per pump, this diminishes the appearance of blemishes and redness by balancing the complexion at the source, leaving the skin hydrated, healthy, and balanced.
UPC: 9421907629230
Key Benefits
- Proven to inhibit detrimental bacteria that lead to blemishes, calming congestion at its source.
- Floods the skin with probiotics, the good bacteria that are essential for skin health.
- Hydrates and calms inflammation for a balanced, clear complexion.
Highlights
Highlights
- acne & blemishes
- black heads
- dry skin
- oily skin
- pore size
- razor burn
- redness & irritation
- sensitivity
Clinical Trials
Clinical Trials
- In-vitro testing demonstrated activity against key skin-associated microorganisms, including C. acnes, under controlled laboratory conditions.* In independent in-vivo testing (2020) on subjects with blemish-prone skin, using the product twice daily for 28 days: 79% of participants reported a visible reduction in the appearance of blemishes and breakouts, and 61% reported a visible reduction in the appearance of blackheads.**
- In an independent in-vivo study (2020) on 10 participants, using the product twice daily for 25 days: 90% of participants showed a measurable increase in skin hydration, and 60% showed a measurable decrease in surface sebum.***
- In an independent in-vivo study (2020) on 98 participants with moderate to significant skin concerns, using the product twice daily for 28 days: 81% of participants who reported dry areas at baseline reported low or no presence at day 28, 61% of participants who reported visible redness at baseline reported low or no presence at day 28, and 58% of participants who reported oiliness at baseline reported low or no presence at day 28.****
* In-vitro test investigating the activity of Micrococcus luteus Q24 against key skin-associated microorganisms (including C. acnes) under laboratory conditions. ** Independent in-vivo testing (2020) on 98 participants with moderate to significant skin concerns, using the product twice daily for 28 days. ***Independent in-vivo testing (2020) on 10 participants, using the product twice daily for 25 days. **** Independent in-vivo testing (2020) on 98 participants with moderate to significant skin concerns, using the product twice daily for 28 days.
Ingredients
Ingredients
Micrococcus luteus
A first-of-its-kind patented live probiotic strain that naturally lives on human skin and inhibits key pathogenic bacteria. It is proven to inhibit the bacteria associated with blemishes while balancing the skin microbiome for optimal skin health and condition.
See Full Ingredients List See Full Ingredients List
live skin probiotic ingredients: caprylic/capric triglyceride, silica dimethyl silylate, polysorbate 80, micrococcus2, trehalose activating crème ingredients: aqua/water/eau, coco-caprylate, glycerin, glyceryl stearate se, cetearyl alcohol, cetearyl wheat straw glycosides, xanthan gum, sodium stearoyl glutamate, dehydroacetic acid, citric acid, benzyl alcohol, parfum (fragrance), limonene, linalool
How To Use
How To Use
- Dispense 1 pump from either side and mix, activating the live probiotic in the formula. While this can be used as a spot treatment, the true benefits are seen when used over the full face. Suitable for morning and evening use.
Complete the Routine
Complete the Routine
Shipping & Returns
Shipping & Returns
Bluemercury.com purchases can be returned free of charge to your local store or by mail within 90 days of purchase. Exchanges may only be completed in-store.
BlueRewards members receive free standard shipping on all orders.
